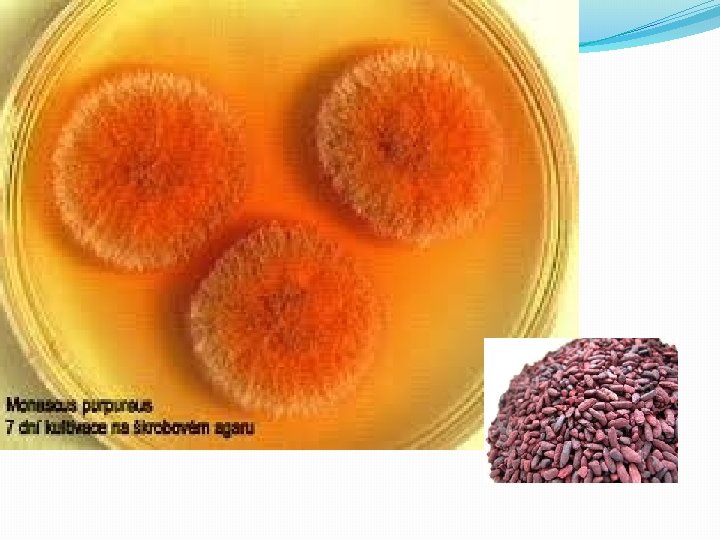

MIKROBIOLOGI KAMRIANTI RAMLI S Pd M Pd 085

MIKROBIOLOGI KAMRIANTI RAMLI, S. Pd. , M. Pd 085 255 582 876

Pengertian Mikrobiologi berasal dari kata mikro (kecil atau renik) Bio (hidup) dan logos (ilmu) Mikrobiologi merupakan bidang ilmu yang mengkaji tentang mikrobia seperti virus, archaea, bakteri, fungi, algae, dan protozoa

Antonie van Leeuwenhoek 1632 -1723 ? Penemu mikroskop Pertama melihat fungi, bakteri dan protozoa

Peranan Mikrobiologi �Lingkungan Ø Bertanggungjawab memelihara kesuburan tanah Ø Membersihkan lingkungan dari senyawa-senyawa toksik Ø Ada yang bertindak sebagai bahan pengontrol biologis melawan penyakit tanaman • Penelitian Ø Model organisme untuk penelitian proses biokimia dan genetika

�Kedokteran Ø Menghasilkan antibiotik dan berbagai obat-obatan • Makanan Ø Digunakan dalam pembuatan anggur dan minuman, keju dan roti • Bioteknologi Ø Mensintesis berbagai senyawa kimia, misalnya aseton, asam asetat, dan asam organik lainnya

Kedudukan Mikrobiologi diantara ilmu-ilmu lainnya Biologi Botani Bakteriologi Mikrobiologi Immunologi Mikologi Pikologi Zoologi Protozologi Virologi

Sejarah Perkembangan Mikrobiologi �Kontroversi doktrin Generasi Spontan 1. Aristoteles (384 -322 SM) MH hidup berasal dari tanah 2. Samson dan Virgil (40 SM), mendukung teorinya dengan memaparkan temuannya membuat lebah dari madu 3. Timbul doktrin generasi spontan yang menyatakan bahwa ulat merupakan penjelmaan daging Doktrin ini bertahan hingga abad ke 17

�Reputasi Akhir doktrin Generasi Spontan Ilmuan yang menyanggah teori Generasi spontan 1. Fransisco Redi (1626 -1697) ulat yang ada didaging akibat telur lalat yang hinggap pada daging yang membusuk 2. Lazzarro Spallanzani (1713 -1781) mikrobia tumbuh pada bahan makanan bersumber dari udara yang mengandung mikrobia 3. Louis Pasteur (1822 -1895) udara terdapat banyak partikel-partikel kecil yang tidak tampak oleh mata telanjang

�Penemuan Peran Mikrobia sebagai Penyebab Penyakit 1. Tahun 1813 dibuktikan jamur tertentu dapat menyebabkan penyakit pada gandum 2. Berkeley (1845) penyakit kentang di Irlandia membawa malapetaka 3. 1836, Agustino Bassi de Lodi, jamur mempengaruhi penyakit khusus serangga. Penyakit ulat sutera disebabkan oleh jamur Beauveria bassiana 4. Sconlein memaparkan penyakit kulit manusia akibat infeksi jamur

�Koch dan Teori Kuman Penyebab Penyakit 1. Koch menggunakan tikus rumah sebagai bahan penelitian mengenai penyakit antraks

Postulat Koch, berbunyi Ø Organisme penyebab penyakit harus selalu ada pada hewan yang terkena penyakit dan tidak ditemukan pada hewan yang sehat Ø Organisme yang terdapat dalam tubuh hewan tersebut harus dapat ditumbuhkan dalam biakan murni Ø Biakan murni tersebut harus dapat diinokulasikan pada hewan yang sama dan menimbulkan gejala yang sama pula Ø Penyebab penyakit tersebut harus dapat diisolasi kembali dari hewan percobaan dapat ditumbuhkan kembali di laboratorium, dan menunjukkan organisme yang sama dengan yang diperoleh sebelumnya

Postulat Rivers > Virus 1. Agen virus harus ditemukan dalam cairan tubuh inang yang sakit atau di dalam sel memperlihatkan lesi spesifik 2. Agen virus yang diperoleh dari inang terinfeksi harus menimbulkan penyakit spesifik pada hewan maupun tumbuhan atau menunjukkan bukti infeksi melalui pembentukan antibodi terhadap virus tersebut. 3. Virus yang diisolasi dari hewan percobaan harus dapat ditularkan ke hewan peka lainnya dan menimbulkan gejala penyakit yang sama

Pertemuan Kedua MORFOLOGI DAN ANATOMI PROKARIOTIK


Struktur Sel Prokariotik: Bakteri fili sitoplasma flagella ribosom Dinding sel mesosom

Ukuran Sel Prokariotik �Secara umum berkisar dari 0, 1 – 20 µm �Paling kecil adalah Paramecium sp berkisar 200 nm �Paling besar adalah Epulopiscium fishelsoni ukurannya 1 juta kali dari bakteri pada umummya. Cat: 1 µm = 1/1000 atau 0, 001 mm atau 1/10. 000 atau 0, 0001 cm

Bentuk Sel Prokariotik Ferdinand Cohn membagi bakteri berdasarkan ciri morfologinya, yaitu: a. coccus, berbentuk bundar atau bulat b. Basil, berbentuk batang atau silinder c. Spiral, berbentuk batang bengkok atau melingkar d. Filamen, berbentuk benang atau filamen

Susunan Kelompok Sel Bakteri �Monococcus, coccus sendiri �Diplococcus atau Diplococci, pembelahan bakteri yang tetap bertautan dan berpasangan �Tetracoccus, membagi diri dalam dua arah yang membentuk sudut siku-siku dan tiap kelompok tersusun atas 4 sel

�Sarcina, membagi diri ke arah 3 bidang, dengan sudut siku-siku satu sama lain, yaitu tiap-tiap kelompok bakteri tersusun sebagai kubus �Streptococcus, coccus yang berantai, yaitu pembelahan sel terjadi konstan paralel sehingga membentuk rantai

�Filamentus, kelompok bakteri yang membentuk hifa palsu, mis golongan Actinomycetes �Bacillus, Streptobacillus, Spirillum yaitu pembelahan melintang terhadap axis longitudinal selnya, lalu terbentuk sel anakan

Struktur Sel Bakteri v. Struktur tidak tetap komponen yang dimiliki oleh beberapa sel bakteri tetapi tidak semua sel mis: dinding sel, flagel, fili, kapsul, lapisan lendir, vakuola gas, spora v. Struktur tetap komponen yang dimiliki oleh semua sel bakteri mis: membran sitoplasma, komponen genetik, ribosom

Dinding Sel �Fungsinya memberi bentuk, memberi kekuatan sel, memelihara tekanan osmosis cairan intraseluler, komunikasi antar sel, pembelahan dan pertumbuhan sel �Memiliki peptidoglikan yaitu homopolimer dengan komposisi dan struktur khusus yang disintesis oleh sel prokariotik


Perbedaan antara Dinding Sel Bakteri Gram negatif dan Gram positif Komponen Dinding sel gram + Dinding sel gram - Peptidoglikan Berlapis tebal Berlapis tipis Tetrapeptida peptidoglikan Kaya akan lisisn Semua mengandung meso -asam diaminopimelat Ikatan silang peptidoglikan Umumnya melalui pentapeptida Ikatan langsung Asam teikoat Ada Tidak ada Asam teikuronik Ada Tidak Ada Lipoprotein Tidak ada Ada LPS Tidak ada Ada Membran luar Tidak ada Ada Ruang periplasmik Tidak ada Ada

Mekanisme Pengecatan Gram 1. Mula-mula sel diwarnai dengan suatu zat warna basa yaitu kristal violet 2. Dicuci dengan air mengalir 3. Diberi iodium (lugol) sehingga terbentuk suatu kompleks kristal violet iodin dalam sel (warna sel semakin kuat) 4. Lalu diberi alkohol aseton, untuk zat warna yang tidak kuat akan terlepas (gram -) sehingga transparan, gram + akan berwarna biru 5. Lalu diberi warna safranin, akan diserap oleh gram – sehingga berwarna merah, gram + berwarna biru kristal violet


PERTEMUAN KETIGA

Membran Sitoplasma �Tebal kira-kira 7, 5 nm (0, 0075 µm) �Terdiri dari fosfolipid (20 -30%) dan protein (50 -70%) �Fungsi permebialitas dan respirasi

Flagella �Ukuran 20 nm �Terdiri atas filamen, pencantel, dan badan dasar �Berputar dengan kecepatan 3000 putaran permenit �Fungsi : menjauh dari oksigen, menuju kearah cahaya, magnet, dan kemotaksis

Flagella dibedakan berdasar kedudukannya �Monotrik, satu flagel melekat diujung sel �Lopotrik, lebih dari dua flagel melekat diujung sel �Amphitrik, satu flagel melekat dikedua ujung sel �Kopotrik, banyak flagel melekat dikedua ujung sel �Peritrik, banyak flagel menyebar pada permukaan sel �Atrik , tidak mempunyai flagel

Fili dan Fimbria �Organel tambahan bagi bakteri garam – �Fili adalah benang-benang pendek lurus dan kecil �Fimbria adalah rambut �Fungsi fili untuk pemindahan materi genetik, pelekatan inang (kawin), hanya jantan punya fili �Fimbria berfungsi mencegah ditelan oleh fagositosis

Glikokaliks �Mengelilingi dinding sel bakteri �Terdiri atas 1. Kapsul 2. Lapisan slime 3. Lapisan S

Kapsul �Permukaan dinding sel ditutupi oleh suatu lapisan �Fungsinya: 1. Membantu mencegah kekeringan sel 2. Bertindak sebagai penghalang ion-ion logam toksik masuk ke dalam sel 3. Mencegah infeksi oleh bakteriofage 4. Membantu perlekatan 5. Membantu sel terhadap pagositosis

Lapisan Slime �Tidak berikatan kuat dengan dinding sel �Fungsinya melindungi sel terhadap kekeringan dan kehilangan nutrien

Lapisan S/protein kristallin �Ditemukan pada beberapa jenis gram – dan + �Fungsi belum diketahui

Bentuk Sel Dorman Bakteri �Spora dibentuk di dalam sel (endospora) dengan dinding yang tebal dan tahan pemanasan, mis: Clostridium dan Bacillus �Systa dinding tebal, tidak tahan pemanasan, mis: Azotobacter vinelandii

Arhaea �Membrannya mengandung protein tinggi dan lipida yang beragam �Tidak mengandung peptidoglikan, hanya pseudopeptidoglikan �Contoh: Sulfolobus sp, hidup diatas 90°C

PERTEMUAN KEEMPAT

MORFOLOGI DAN ANATOMI MIKROBIA EUKARIOTIK FUNGI KAPANG KHAMIR ALGA PROTOZOA

FUNGI Ciri-ciri fungi 1. Mempunyai inti sel 2. Membentuk spora 3. Tidak berklorofil 4. Heterospora 5. Saprofit 6. Berkembang biak secara sexual (plasmogami, karyogami) dan aseksual (pembelahan sel, pertunasan, fragmentasi)

Struktur Tubuh Fungi

Reproduksi secara seksual �Plasmogami merupakan mekanisme peleburan antara dua protoplas yang kemudian diikuti dengan peleburan intinya �Karyogami terjadi jika dua inti kompatibel bersama-sama melakukan fusi inti

Tipe Utama Fungi berdasar kebutuhan karbon dan energi �Saprofitik menggunakan nutrien dan sisa-sisa tumbuhan/hewan mati �Parasitisme memanfaatkan jaringan hidup tanaman/hewan sehingga dapat menganggu inang �Simbiosis Hidup pada jaringan hidup dan memberi keuntungan pada inang

Klasifikasi dan sifat utama beberapa fungi Kelompok Nama Umum Tipe Hifa Genus Tipe spora seksual Ascomycetes Fungi kantung Septa Neurospora, Saccharomyces, Morcella Askospora basidiomycetes Jamur Septa Amanita, agaricus Basidiospor Zygomycetes Jamur roti Senositik Mucor, Rhizopus Zygospor Oomycetes Jamur air Senositik Allomyces Oospor septa Penicillium, Aspergillus, Candida Tidak diketahui Deuteromycetes Fungi imperfekti

Septa Senositik


KELAS ASCOMYCOTA Ciri-Ciri �Ada yang berjamur bersel satu, Saccharomyces sp �ada yang bersel banyak dengan hifa bersekat dan berinti banyak, Penicillium sp �Bersel banyak membentuk tubuh buah, Xylaria sp dan Nectria sp �Reproduksi aseksual membentuk spora, tunas �Reproduksi seksual dengan membentuk askokarp


KELAS BASIDIOMYCOTA �Tumbuh di musim penghujan �Umumnya tumbuh di batang pohon lapuk/lembap �Mempunyai tubuh buah �Reproduksi seksual secara basidiospora

Contoh Zygomycetes

KELAS ZYGOMYCOTA/PHYCOMYCOTA �Hifa tidak bersekat (senositik) �Hidup saprofit, parasit �Reproduksi aseksual membentuk sporangium �Contoh: Rhizopus oryzae (jamur tempe)

KELAS OOMYCOTA �Hifa tak bersekat �Reproduksi aseksual : pembentukan zoospora �Reproduksi seksual : peleburan sel telur haploid dan inti sperma haploid �Contoh : Phytophthora nicotinae

KELAS DEUTEROMYCOTA �Hifa bersekat �Beberapa membentuk tubuh buah �Ada yang hidup parasit �Reproduksi aseksual dengan konidiospora, blastospora, artospora �Reproduksi seksual belum diketahui �Contoh : Epidermophyton floocosum (kurap)

Tugas �Carilah peranan fungi baik yang merugikan maupun menguntungkan, sertai contoh spesiesnya.


Ciri-ciri Khamir 1. Lebar 1 -5 µm dan panjangnya 5 -30 µm atau lebih 2. Bentuk uniseluler, bulat, oval, silinder, ogival, segitiga melengkung, berbentuk botol, lemon/apikulat, pseudomiselium, dsb 3. Tidak punya flagella 4. Koloni halus tampak berkilauan 5. Tidak dapat melakukan fotosintesis 6. Dinding sel kaku

Bentuk-bentuk sel Khamir BULAT SILINDER TRIANGULAR APIKULAT OVAL OGINAL BOTOL PSEUDOMISELIUM

Reproduksi Khamir: Pertunasan Suatu saluran terbentuk dari vakuola didekat nukleus menuju dinding sel, dinding sel mengalami penipisan, sehingga protoplasma akan tersembul keluar lalu membesar dan diisi dengan komponen-komponen nukleus dan sitoplasma dari induknya melalui saluran yang terbentuk. Tunas tumbuh dan membentuk dinding sel baru

Tugas �Carilah manfaat dari Khamir

Kapang merupakan fungi multiseluler yang mempunyai filamen dan pertumbuhannya pada substrat mudah dilihat karena penampakannya yang berserabut seperti kapas

REPRODUKSI KAPANG Spora kapang Spora aseksual Konidiospora Sporangiospora Oidium/arthrospora Klamidiospora blastospora Spora seksual Askospora Basidiospora zygospora

Konidiospora yaitu spora yang dibentuk diujung Sporangiospora terbentuk di dalam kantung spora Oidium terjadi karena segmentasi pada ujung-ujung hifa Klamidiospora terbentuk pada selsel vegetatif Blastospora terbentuk dari tunas pada miselium yang kemudian tumbuh menjadi spora

Macam-Macam Spora Aseksual

Macam-Macam Spora Seksual

Askospora yaitu spora yang dibentuk diaskus Basidiospora yaitu spora yang dibentuk dalam basidium Zygospora terbentuk apabila ujung-ujung dua hifa yang seksual

ALGA Ciri-ciri Alga 1. Mengandung klorofil 2. Ada yang berukuran mikro dan makroskopik 3. Bersifat uniseluler, koloni 4. Bersifat motil (dpt bergerak)/non motil 5. Seksual (konjugasi gamet sel) aseksual (pembelahan biner)

Jenis-Jenis Alga �Chlorophyceae/alga hijau uniseluler motil hingga lembaran, filamen, senositik. Reproduksi seksual konjugasi Contoh: Clamydomonas �Chrysophyta/alga coklat keemasan umumnya berflagella, ada yang amuboid, uniseluler, koloni, filamen, reproduksi seksual isogami contoh: Navicula

�Dinoflagellata uniseluler, reproduksi aseksual dengan pembelahan sel secara memanjang Contoh: Noctiluca miliaris �Euglenophyta uniseluler, hidup heterotrof dan autotrof, ukuran panjang sel 10 µm – 500 µm Contoh: Euglena sp

Protozoa Ciri-ciri 1. Tidak punya dinding sel 2. Membran plasma dua lapis 3. Punya dua atau lebih inti

4 filum Protozoa �Mastigophora (flagellata) memiliki flagellata secara umum Contoh : Euglena viridis �Sarcodina (membentuk pseudopodia) tidak memiliki sifat tetap, berkembang biak dengan pembelahan biner Contoh : Entamoeba hystolica

�Ciliata bentuknya bulat, terompet, dan ginjal berkembangbiak aseksual dengan pembelahan melintang, seksual dengan konjugasi Contoh: Paramecium caudatum �Sporozoa bersifat parasit obligat, tidak punya alat gerak Contoh : Plasmodium vivax
- Slides: 73